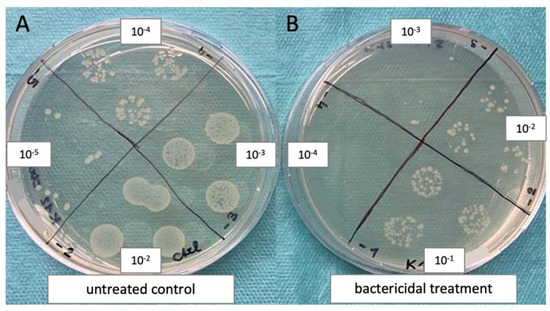

Abstract
The increase in antibiotic resistance represents a major global challenge for our health systems and calls for alternative treatment options, such as antimicrobial light-based therapies. Blue light has shown promising results regarding the inactivation of a variety of microorganisms; however, most often, antimicrobial blue light (aBL) therapy is performed using wavelengths close to the UV range. Here we investigated whether inactivation was possible using blue light with a wavelength of 475 nm. Both Gram-positive and -negative bacterial strains were treated with blue light with fluences of 7.5–45 J/cm2. Interestingly, only some bacterial strains were susceptible to 475 nm blue light, which was associated with the lack of RecA, i.e., a fully functional DNA repair mechanism. We demonstrated that the insertion of the gene recA reduced the susceptibility of otherwise responsive bacterial strains, indicating a protective mechanism conveyed by the bacterial SOS response. However, mitigating this pathway via three known RecA inhibiting molecules (ZnAc, curcumin, and Fe(III)-PcTs) did not result in an increase in bactericidal action. Nonetheless, creating synergistic effects by combining a multitarget therapy, such as aBL, with an RecA targeting treatment could be a promising strategy to overcome the dilemma of antibiotic resistance in the future.
1. Introduction
According to the ‘Antibiotic Resistance Threats Report 2019’ of the Centers for Disease Control and Prevention (CDC), more than 35 000 deaths per year are attributed to infectious diseases with antibiotic resistant microbes in the US alone [1]. There is a general agreement among health care professionals and scientists that antibiotics need to be used less frequently and more cautiously. Hence, new treatment options are needed and actively searched for. The germicidal properties of ultraviolet (UV) light (both UV-C (100–280 nm) and UV-B (280–315 nm)) are well documented. They are mainly based on the absorption by nucleic acids at approximately 260 nm, which causes cellular damage, including the formation of cyclobutane pyrimidine dimers (CPDs), pyrimidine (6–4) pyrimidone photoproducts (6–4 PPs) and the deamination of thymine [2,3,4,5,6]. Thereby, UV irradiation triggers a multitude of negative side effects, such as erythema, inflammation, temporary suppression of the immune function, and photoaging, and it contributes to carcinogenesis [7,8,9,10,11,12,13,14,15]. Nevertheless, its bactericidal properties have been demonstrated multiple times and have been used for numerous applications, e.g., the treatment of acne, eczema, vitiligo and psoriasis [16,17,18].
To bypass the negative effects of UV light, energy-rich blue light comes into the focus of research, termed as antibacterial blue light (aBL) therapy. Using visible light with longer wavelengths than UV light, in the range of 380–500 nm, has already been shown to be effective in vitro as well as in vivo for infection control [19,20,21,22,23,24]. Still, the majority of published data focuses on blue light with wavelengths close to the UV spectrum. In the present study, we investigated whether it is possible to inactivate bacteria using blue light with a relative long wavelength of 475 nm. This wavelength has already been used to significantly release nitric oxide (NO) bound to heme proteins, such as cytochrome c oxidase (Dungel et al. 2008), and promote wound healing processes (Dungel et al. 2014) [25,26].
The antibacterial effects of aBL are based on the well-known mechanisms of photodynamic therapy, the generation of intracellular reactive oxygen species (ROS) by the excitation of light-activated photosensitizers, but aBL uses endogenous photosensitizers, such as porphyrins and flavins inside the cells instead of exogenously applied ones [27,28]. As the effects of aBL on mammalian cells are reported to be less detrimental than with UV light, further research is necessary [29,30].
In eukaryotes, in most cases, DNA lesions are recognized and repaired by the nucleotide excision repair system (NER), so they do not entail detrimental consequences [31]. In prokaryotes, the presence of DNA lesions activates their own DNA damage programs through the activation of the so-called SOS response by the protein RecA. Thus, inhibition of the SOS response would increase the susceptibility of bacteria against antibacterial therapies. Furthermore, besides its antimicrobial potential, a major advantage of aBL therapy is the recently emerging wound healing promoting effects.
aBL therapy with longwave blue light could combine regenerative as well as antimicrobial effects [25,26]. Thus, the aim of the present study was to investigate the antimicrobial potential of blue light of 475 nm and to evaluate the role of the bacterial SOS response, especially RecA, in the responsiveness to aBL therapy in order to create a future protocol for enhancing bactericidal effects.
2. Materials and Methods
2.1. Bacterial Strains and Chemicals
All chemicals were purchased from Sigma-Aldrich, Burlington, USA, if not stated otherwise. Bacterial strains used in this work were Escherichia coli K12 (Addgene, Watertown, MA, USA), Escherichia coli TOP10 (Invitrogen, Carlsbad, CA, USA), Escherichia coli NEB 5α (New England Biolabs, Ipswich, USA) and Staphylococcus carnosus (kindly provided by Dr. K. Plätzer, University of Salzburg). The respective strains were chosen based on the presence of the recA gene in their genome. A list stating which strains carry a functional copy can be seen in Table 1.

Table 1.
Bacterial strains used in this work and the presence of the gene recA.
2.2. Culture Conditions
The bacterial strains were cultivated in 4 mL Lysogeny broth (LB, BP1426-2, Thermo Fisher Scientific Inc., Waltham, MA, USA) under aerobic conditions at 37 °C and 250 rpm on an orbital shaker (Edmund Bühler® TH15, Hechingen, Germany).
2.3. Light Source
LED devices emitting 475 nm blue light (REPULS Lichtmedizintechnik GmbH, Vienna, Austria) were used for all experiments. The lamps radiate with a pulse rate of 50% and an intensity of 50 mW/cm2 as determined with a USB2000 spectrometer (Ocean Optics, Orlando, FL, USA). The repetition frequency was 2.5 Hz, while the irradiation duration varied from 5 to 30 min, resulting in a fluency of 7.5–45 J/cm2. The light source was placed directly on top of the plates with the lids closed. Absorption of the polystyrol lids was negligible.
2.4. Blue Light Treatment
All experiments with bacteria were performed during their exponential growth phase. Overnight cultures were diluted in fresh medium and optical density was measured at a wavelength of 600 nm (OD600) using a spectrophotometer (HITACHI® Ratio Beam Spectrophotometer U-5100, Tokyo, Japan) and again after 30–40 min of incubation at 37 °C, 200–250 rpm.
2.4.1. Planktonic Assays
For planktonic assays, bacterial suspensions were centrifuged for 5 min at maximum speed in a table centrifuge. After discarding the supernatant, the pellet was resuspended in PBS until it was thoroughly dispersed. Next, the optical density was measured and the bacterial concentration was determined, using the formular OD600 = 1.0 = 8 × 108 CFU/mL. The suspension was diluted in PBS to reach a final concentration of 1 × 107 CFU/mL and 250 µL/well were transferred into several 24-well plates. One plate was kept in the dark for a total duration of 30 min as a control, and the remaining plates were irradiated with blue light for 5–30 min respectively, resulting in a fluence of 7.5–45 J/cm2. After the treatment, individual serial dilutions were prepared from each well. Next, three drops of 20 µL of four dilutions were transferred to LB-agar plates according to the method published by Miles and Misra (an example image is shown in Figure 1) [32]. Plates were incubated at 37 °C overnight, and on the next day, distinct colonies were counted and total colony forming units (CFU) were calculated.
Figure 1.
Example of the bacteria quantification method used in the present work: Three drops of 20 µL of four different bacterial dilutions were grown overnight on LB-agar plates. On the next day, distinct colonies were counted in at least two sections, and the colony forming units (CFU) were calculated. Here, E. coli K12 was either untreated (A) or treated with ciprofloxacin (B).
2.4.2. Assays on Agar Plates
In order to simulate a more complex solid environment, bacteria were also grown and treated on agar plates. Overnight cultures were diluted and after 30 min, the concentration was adjusted to 1 × 107 CFU/mL. A serial dilution was prepared in growth medium and 20 µL drops were transferred onto agar plates. LED lamps were placed directly on top of the petri dishes with their lids closed. Cells were further handled as described above. A schematical illustration of both protocols is shown in Figure 2.

Figure 2.
Visualization of two different workflows of blue light treatment. (A) planktonic assay: After preparing a bacterial suspension in PBS, aliquotes were transferred into 24-well plates and irradiated while in planctonic suspension. Next, serial dilutions were made using PBS as a dilutant, and 20 µL aliquots were transferred onto agar plates. (B) Agar plate assay: In order to simulate a more complex environment during treatment, bacteria were treated when growing on agar.
2.5. Testing the Role of RecA Inhibitors for Protection against 475 nm Blue Light
Three different compounds that were already reported to inactivate one or more components of the SOS response were used to test if the efficacy of aBL therapy can be increased in the aBL-resistant bacterial strain E. coli K12: zinc acetate (ZnAc), Fe(III)-PcTs and curcumin (Cur) [33,34,35]. All experiments were additionally performed using E. coli TOP10, which lacks a functional recA gene (recA− control). First, minimal inhibitory concentrations were determined (Supplementary Material, Figures S4–S6), defined as the highest concentration of the respective compound that did not decrease bacterial viability. Working concentrations were 500 µM ZnAc, 300 µM Fe(III)-PcTs and 10 µM curcumin, respectively.
Planktonic bacterial cultures were incubated with the respective working concentration or PBS as control for 1 h at 37 °C on a shaker at 200–250 rpm. Next, the bacterial count was determined via OD600 measurements and adjusted to 1 × 107 CFU/mL in LB-medium in Eppendorf tubes. Inhibitors were present in all subsequent steps. Before exposing the cells to blue light, a 1:10 serial dilution of each bacterial suspension was prepared, and three 20 µL replicates were pipetted on LB-agar plates. In addition to regular plain LB-agar plates, the experiments were also conducted on plates where the agar was supplemented with the same concentration of the respective RecA inhibiting substance to ensure long-time exposure. Afterward, the plates were irradiated with a fluence of 30 J/cm2 (20 min) and then incubated overnight at 37 °C.
2.6. Insertion of a Plasmid Carrying the Gene RecA into RecA Negative (RecA−) Bacterial Strains and Subsequent Blue Light Exposure
Two recA− bacterial strains (E. coli NEB 5α and E. coli TOP10) that were purchased already competent were both transformed with one of two plasmids: (1) the first one carrying the gene recA (termed RecA-plasmid) or (2) an identical plasmid expressing gfp instead (termed Ctrl-plasmid) under the control of the same recA promoter. The plasmid used was pMK-RQ (Invitrogen, USA). For the transformation, we followed the One Shot® chemical transformation protocol by Invitrogen, Carlsbad, USA. Cells were irradiated on agar plates with 30 J/cm2 blue light (20 min) as described in Section 2.4.2.
2.7. Statistical Analysis and Calculation of Logarithmic Reduction Values
All experiments were tested for statistical significance using Ordinary One-way ANOVA with Dunnett’s multiple comparisons test by GraphPad Prism 9 (GraphPad Software, Inc.) apart from one experiment evaluating the effects of aBL on plasmid transformed bacterial strains, where a paired t-test was used. Statistical significance was accepted at p ≤ 0.05. Reduction of bacterial count is expressed as logarithmic reduction values (LRV), which were calculated via the following formula:
3. Results
3.1. Culture Conditions during aBL Treatment Determine Therapy Outcome
The effects of 475 nm blue light exposure was first tested in planktonic suspension in PBS. Notably, while E. oli K12, S. carnosus and E. coli TOP10 were not significantly reduced, E. coli NEB 5α showed a mean reduction of CFUs by 0.26-log10 units (p = 0.009) after being irradiated with a fluence of 45 J/cm2 (30 min). These results would suggest that overall, the used bacterial strains are not or minimally susceptible to 475 nm blue light, at least when treated in a planktonic suspension in PBS (Figure 3). However, when blue light was applied on the same four bacterial strains directly on LB-agar plates, representing a more complex environment, the results differed. While E. coli K12 and S. carnosus did not respond to increasing doses of blue light, the CFU of recA− strains (E. coli TOP10 and E. coli NEB 5α) were significantly decreased after a dose of 7.5 J/cm2 (LRVE. coli TOP10 = 1.20, p < 0.0001) and 15 J/cm2 (LRVE. coli NEB 5α = 0.36, p = 0.001) respectively. While E. coli NEB 5α was reduced by 0.74-log10 units after 45 J/cm2 (p < 0.0001), it resulted in a 2.40-log10 CFU decline in E. coli TOP10 (p < 0.0001). To conclude, solely strains without a functional copy of the gene recA were inactivated by 475 nm blue light when the treatment was conducted in LB-medium (Figure 4).

Figure 3.
Blue light therapy conducted with four different bacterial strains in a planktonic suspension in PBS for various durations: A slight reduction of CFUs was only achieved in E. coli NEB 5α (D) LRVE. coli NEB 5α = 0.26, p = 0.009) after irradiation with 45 J/cm2, while E. coli K12 (A), S. carnosus (B) and E. coli TOP10 (C) remained unaffected. The irradiated groups were compared to a group that was left in the dark (0 J/cm2). Black dots: 0 J/cm2, blue squares: 7.5 J/cm2, blue triangles: 15 J/cm2, blue circles: 30 J/cm2, blue hexagons: 45 J/cm2. Mean ± SEM, n = 4, ** p ≤ 0.01.

Figure 4.
Exposure to different doses of 475 nm blue light on LB-agar: one Gram−(+) bacterial strain (S. carnosus (B)) and three Gram−(−) strains (E. coli K12 (A), E. coli TOP10 (C), E. coli NEB 5α (D)) were irradiated with either 0, 7.5, 15, 30 or 45 J/cm2 of blue light. While the irradiation was not able to reduce the CFU of E. coli K12 and S. carnosus, the two strains with a defective copy of the recA gene (E. coli TOP10 and E. coli NEB 5α) were successfully diminished. At 45 J/cm2, E. coli TOP10 was lowered by 2.40-log10 CFU (p < 0.0001) and E. coli NEB 5α by 0.74-log10 CFU (p < 0.0001). Black dots: 0 J/cm2, blue squares: 7.5 J/cm2, blue triangles: 15 J/cm2, blue circles: 30 J/cm2, blue hexagons: 45 J/cm2. Mean ± SEM, n = 5, *** p ≤ 0.001, **** p < 0.0001.
Since riboflavin is discussed as a potential key photosensitizer in blue light therapy, it was tested whether the presence of riboflavin in the LB-medium is the decisive factor responsible for the observed differences. However, supplying PBS with the same content of riboflavin as LB-medium (0.44 µg/mL, determined via fluorescence measurements, supplemental material, Figure S1) did not affect therapy outcome (Supplementary Material, Figure S3). Furthermore, there was no difference in riboflavin secretion among the used strains (Supplementary Material, Figure S2), suggesting that susceptibility to 475 nm blue light exposure is obtained by mechanisms other than riboflavin overproduction. Notably, a striking difference between the resistant and the susceptible strains was the presence or absence of the gene recA.
3.2. Resistance toward 475 nm Blue Light Was Not Affected by RecA Inhibitors (ZnAc, Curcumin or Fe(III)-PcTs)
First, the minimal inhibitory concentration (MIC) of the inhibitors was determined (Supplementary Material, Figures S4–S6). Pretreating bacteria with either ZnAc, curcumin or Fe(III)-PcTs did not reduce the resistance of the recA+ strain E. coli K12, neither on plain agar plates, nor when the same concentration of the named compounds was also present in the agar plates to ensure long-term exposure (Figure 5). Likewise, the antimicrobial effects of the treatment were not enhanced in the recA− strain E. coli TOP10. These results suggest that RecA inactivation might have been incomplete or that other factors contribute to the resistance toward 475 nm aBL. Detailed data can be found in the Supplementary Material (Figures S7–S9).

Figure 5.
Exposure to 475 nm blue light after pretreatment with various RecA-inhibiting substances: E. coli K12 (A,B); contains the gene recA in its genome) and E. coli TOP10 (C,D); possesses a deletion in the gene recA) were irradiated with 30 J/cm2 blue light alone (aBL, blue squares) or after incubation with 500 µM ZnAc (ZnAc + aBL, lilac triangles), 10 µM curcumin (cur + aBL, orange circles) or 300 µM Fe(III)-PcTs (PcTs + aBL, turquoise circles). A control group was kept in the dark for the duration of the blue light treatment (dark, black circles). The experiment was first conducted on regular LB-agar-plates (A,C) as well as on plates containing the respective compounds (B,D). None of the compounds reduced the resistance of E. coli K12 toward aBL or increased the efficacy in E. coli TOP10. Mean ± SEM, n = 3, **** p < 0.0001.
3.3. Prevention of aBL Toxicity by RecA Overexpression
In two recA− bacterial strains, normally susceptible to 475 nm blue light treatment, transformation with a plasmid carrying the recA gene (RecA-plasmid) showed a protective effect (Figure 6). Wild-type E. coli TOP10, which normally shows a high susceptibility to 475 nm aBL (reduction of mean CFU by 99.18% compared to non-treated group, p < 0.0001), after transformation showed a reduction by only 35.21% (p = 0.0148). Transformation with the Ctrl-plasmid resulted in an average decrease of 79.48% (p = 0.0068).

Figure 6.
The effects of exposure to 475 nm blue light were diminished by the insertion of a plasmid carrying recA in both (A) E. coli TOP10 and (B) E. coli NEB 5α by 64 % and 63 %, respectively compared to the non-transformed (wt) group. Cells were irradiated with 30 J/cm2. Ctrl-plasmid indicates groups transformed with an inactive control plasmid. Wild-type dark: black circles, wild-type blue: blue squares, Ctrl-plasmid dark: black triangles, Ctrl-plasmid blue: blue triangles, RecA-plasmid dark: black rhombuses, RecA-plasmid blue: blue hollow circles. Mean ± SEM, n = 4, * p ≤ 0.05, ** p ≤ 0.01, **** p < 0.0001.
Similar data were demonstrated with E. coli NEB 5α. aBL irradiation decreased CFUs of the non-transformed, and the Ctrl-plasmid transformed groups by 76.61 % (p = 0.0039) and 79.64 % (p = 0.0011), respectively. By transforming the strain with the RecA-plasmid, a reduction of only 13.68 % (non-significant) of CFU could be observed, suggesting that the plasmid expressing recA gene provided protection toward aBL.
4. Discussion
During the course of the 20th century, the mortality of certain diseases that were previously considered untreatable, such as syphilis, typhoid fever or plague, was considerably decreased, thanks to the discovery of antibiotics. However, due to the readily available access to these drugs, incorrect use and overuse, we are now faced with the pressing issue of increasing bacterial resistance against antibiotics and a lack of alternative treatment options for a variety of life-threating diseases.
One promising approach could be antimicrobial blue light (aBL) therapy. While the underlying mechanism of bacterial inactivation is still the subject of current research, evidence indicates that light with a wavelength in the blue range (>380 nm) can activate endogenous photosensitizing molecules within the cells (such as flavins and porphyrins) to produce cell-destructing ROS [27,36].
One major advantage of light-based therapies in contrast to antibiotic drugs is a presumably lower probability of the development of resistance due to the in situ multitarget mechanism of action. There are little data about bacterial resistance toward blue light published to date. Guffey et al. reported a decline in the kill rate after four consecutive irradiation cycles with 405 nm on S. aureus. Interestingly, before the decrease in efficacy, the treatment became more efficient with each cycle. Still, the lower bactericidal effects after cycle 4 were statistically significant [37]. Rapacka-Zdonczyk et al. demonstrated that sub-lethal aBL therapy with 411 nm blue light increased treatment tolerance after four consecutive cycles of exposure to aBL and subcultivating. Furthermore, their findings suggest a SOS-response depended, specifically umuC-dependent effect of tolerance acquisition [38]. Similar findings were reported using UV irradiation (254 nm), where a reduction in treatment success was caused by mutations in genes involved in DNA repair and replication [39].
In contrast to previous studies, blue light of longer wavelengths has been shown to trigger positive regenerative effects. Light of 470 nm increased angiogenesis and reduced necrotic damage in an ischemia-disturbed wound healing model in rats [26]. It also enhanced wound healing in an excision wound model [40]. Other groups reported positive effects in the healing of chronic wounds [26,41]. Depending on light parameters, blue light also reduced proliferation of skin cells, aiding in the treatment of hypertrophic scars [42,43]. Thus, we were interested in using blue light with a wavelength of 475 nm and an intensity of 50 mW/cm2 on Gram-positive as well as -negative bacterial strains to test the antimicrobial potential. While two strains were successfully reduced after being irradiated with as little as 7.5 J/cm2 (E. coli TOP10, LRV = 1.20, p < 0.0001) or 15 J/cm2 (E. coli NEB 5α, LRV = 0.36, p = 0.0001), the other two strains remained unresponsive (Figure 4). Interestingly, efficacy depended not only on the bacterial strain but also the environment that the treatment was performed in. When the bacterial suspensions were irradiated in planktonic suspension in PBS, a standard method for photodynamic assays, there was no or a minimal decline in colony forming units (CFU; Figure 3), while the same strains were susceptible to the treatment when treated directly on LB-agar plates (Figure 4). One possible reason for this could be that the two susceptible strains produced excessive amounts of riboflavin, which is the precursor of flavin mononucleotide (FMN) and flavin adenine dinucleotide (FAD) and believed to be one of the major photosensitizing compounds within the cells [27]. However, when measuring the riboflavin content of the cultivation medium after overnight incubation, no significant differences were detected among the different bacterial strains (Supplementary Material, Figure S2). Furthermore, when supplying PBS with the same amount of riboflavin that can be found in LB-medium, the therapy did not result in any reduction of an otherwise receptive strain in regular LB-medium (supplementary material, Figure S3). These results suggest that extracellular riboflavin did not play an integral role in the efficacy of aBL therapy. Besides flavin-based photosensitizers, recently it was also shown that bacteria produce different amounts and types of porphyrins depending on the composition of their growth medium [44]. For example, glutamate in the culture medium can be converted to 5-aminolevulinic acid by bacteria, the precursor of all porphyrins [45]. Therefore, there is also the possibility that the LB-medium contains vital molecules needed for the production of the responsible internal photosensitizing molecules. This is especially important considering the vast variety of host enzymes, proteins and antioxidants present in a clinical setting treating patients. Further experiments are required to identify the reasons for the dissimilarities in the outcomes between the treatment in a planktonic PBS suspension versus on solid agar surface.
However, comparing the genotypes of the strains revealed that those strains that were susceptible to 475 nm blue light (E. coli TOP10 and E. coli NEB 5α) carried a non-functional copy of the gene recA. This gene encodes the key molecule involved in the bacterial SOS response called RecA, which facilitates DNA repair and homologous recombination [46,47]. The protein RecA becomes activated when the replication fork stalls due to DNA damage and stimulates the repressor molecule LexA to cleave itself in order to allow translation of downstream genes involved in the SOS response [48,49,50]. These genes include uvrAB (involved in NER), sulA (inhibits cell division), umuCD (error-prone DNA polymerase V) and many more [51]. Additionally, the expression of the genes recA and lexA themselves are induced in the early phases of the SOS response [52].
It is well known that antibiotics, which act by inhibiting DNA replication, as well as UV rays, ROS and bacteriophages are able to induce this RecA-regulated repair program in bacteria [53,54,55,56,57]. Furthermore, Rapacka-Zdonczyk et al. reported that also aBL therapy with a wavelength of 411 nm and a fluence of 150 J/cm2 triggered the SOS response, most likely due to its ROS-dependent mechanism of action [38].
Preventing the activation of this pathway deprives the cells of DNA repair mechanisms and thereby increases their vulnerability toward bactericidal treatments. Besides that, the SOS response also contributes to resistance development by engaging the error-prone DNA polymerase V as well as by promoting the horizontal gene transfer of plasmids that often contain virulence factors and antibiotic resistance genes [58,59]. Hence, these properties make the targeted modulation of the bacterial SOS response a valid and therapeutically attractive approach for antibacterial treatments.
To investigate the importance of RecA in the bacterial inactivation by blue light, three chemical compounds that were previously reported to inhibit the mentioned protein were tested in their ability to reverse the resistance of E. coli K12.
First, zinc acetate (ZnAc) has been shown to inhibit ciprofloxacin- as well as zidovudine-induced recA gene expression at 200 µM in a Shiga toxin-producing E. coli strain [33]. Sterer et al. found that adding 1 % (w/v) of ZnAc when irradiating a biofilm with a light source emitting a wavelength of 400–500 nm and a dose of 41, 82 and 164 J/cm2 increased the inactivation of malodor-producing bacteria compared to aBL treatment alone [60]. In the present work, 475 nm aBL therapy was performed with a concentration of 500 µM ZnAc with E. coli K12 and E. coli TOP10. After incubating both strains with and without ZnAc for one hour, the bacterial suspensions were irradiated for 20 min, resulting in a fluence of 30 J/cm2. While the CFU of E. coli TOP10 were reduced, the recA+ strain E. coli K12 was not influenced by ZnAc, and no reduction in CFU was observed.
Second, the phenolic compound curcumin was found by Oda et al. to inhibit UV-induced, SOS-regulated umuC (polymerase V) expression in a dose-dependent manner at a 50 % inhibition value of 7.8 µg/mL in Salmonella typhimurium [61]. Moreover, Bellio et al. also saw a diminished SOS response using 4 µg/mL curcumin after inducing it with levofloxacin [35]. Similar to ZnAc, 10 µM curcumin (or 3.7 µg/mL) did also not attenuate the resistance of E. coli K12 toward 475 nm blue light. The reduction of CFUs in E. coli TOP10 was consistent, regardless of the pretreatment with curcumin: LRVE. coli TOP10 aBL = 3.10 (p < 0.0001), LRVE. coli TOP10 aBL + cur = 2.95 (plain LB-agar plates, p < 0.0001) and LRVE. coli TOP10 aBL + cur = 3.08 (supplemented LB-agar plates, p < 0.0001).
Third, the anionic, aromatic molecule Fe(III)-phthalocyanine tetrasulfonate (Fe(III)-PcTs) which is able to bind to the cationic DNA was used. Fe(III)-PcTs was shown to successfully inhibit the SOS response and thereby potentiated the bactericidal effect of ciprofloxacin. It exerted its action through not only blocking the ATPase, DNA binding and strand exchange activities, but also by stopping the autoproteolysis of LexA [34]. Here, a pretreatment with 300 µM Fe(III)-PcTs for one hour before being irradiated with 30 J/cm2 aBL did not reduce the resistance of E. coli K12 toward 475 nm blue light as well.
In summary, interestingly, none of the tested inhibitors showed therapy-enhancing effects, at least under the chosen experimental conditions (Figure 5). We carefully correlated the concentrations with those reported in literature and additionally checked the minimal inhibitory concentrations of every reagent (supplemental material, Figures S4–S6). It is not unusual for drugs targeting a multifunctional protein to require a higher dose in living cells compared to isolated proteins. Nautiyal et al. found a considerable difference between the half maximal inhibitory concentration (IC50) of the RecA inhibitor suramin in regard to isolated RecA protein compared to live bacterial cells [62]. Therefore, we also tested higher concentrations wherever possible. However, the approach via inhibitors had limits, as too high concentrations affected the viability of the cells.
Nonetheless, as the lack of functional recA gene was a striking feature of susceptible strains, we tested another approach to investigate its role by inserting a plasmid carrying the gene. Indeed, transforming recA− strains E. coli TOP10 and E. coli NEB 5α with a recA containing plasmid protected both strains from the bactericidal effects of 475 nm blue light. Faster growing bacterial cultures in general tend to be more susceptible toward antibacterial drug treatments [63,64,65]. Therefore, a control group was transformed with a plasmid containing gfp instead of recA, which excluded effects of altered replication times (supplementary material, Figure S10). These data suggest the importance of recA in the tolerance toward 475 nm blue light and that it could be a worthwhile target for future therapeutic strategies.
5. Conclusions
In conclusion, aBL at 475 nm had a selective effect on the inhibition of bacterial strains. There was a striking difference of efficacy depending on the experimental conditions as well as the genotype of the strains. The data suggest that the SOS response-inducing protein RecA plays an integral role in resistance against 475 nm blue light. The modulation of the bacterial SOS response would not only benefit aBL therapy, but also antibacterial drug treatments, which are still the standard protocol for the care of infections, making it a promising strategy to overcome the dilemma of antibiotic resistance.
Supplementary Materials
The following supporting information can be downloaded at: https://www.mdpi.com/article/10.3390/life12101499/s1, Figure S1: Standard regression of riboflavin, Figure S2: Fluorescence measurements to compare the riboflavin content in the supernatant of different bacterial strains, Figure S3: Antibacterial blue light therapy conducted in PBS which was supplemented with 0.44 µg/ml riboflavin, Figure S4: Growth curve of E. coli K12 incubated with various concentrations of ZnAc measured in a clear 24-well plate on a plate reader, Figure S5: Incubating E. coli K12 with Fe(III)-PcTs with concentrations up to 10 mM did not result in reduction of CFUs, Figure S6: Exposing E. coli K12 to increasing concentrations of curcumin, Figure S7: Antimicrobial blue light therapy in LB-medium with or without ZnAc pretreatment, Figure S8: Pretreatment with 10 µM curcumin before aBL therapy with a fluency of 30 J/cm2 did not cause any deviations from the usual response to the therapy in E. coli K12 and E. coli TOP10, Figure S9: Bacterial inactivation by aBL therapy combined with 300 µM Fe(III)-PcTs in an effort to inhibit RecA, Figure S10: Growth curve of transformed bacterial strains.
Author Contributions
Conceptualization, A.H., L.K. (Lisa Karner), M.M. and P.D.; methodology, A.H., L.K. (Lisa Karner) and M.M.; formal analysis, M.M.; investigation, A.H., L.K. (Lisa Karner), L.K. (Leonie Krausgruber), M.M. and P.D.; resources, J.G. and P.D.; writing—original draft preparation, M.M. and P.D.; writing—review and editing, A.H., L.K. (Lisa Karner), M.M., J.G. and P.D.; visualization, M.M.; supervision, A.H. and P.D.; project administration, M.M. and P.D.; funding acquisition, P.D. All authors have read and agreed to the published version of the manuscript.
Funding
This research was funded by The Austrian Research Promotion Agency FFG, grant number 853128.
Institutional Review Board Statement
Not applicable.
Informed Consent Statement
Not applicable.
Data Availability Statement
Data supporting reported results are available upon request.
Acknowledgments
We thank Carina Wagner for administrative and technical support.
Conflicts of Interest
The authors declare no conflict of interest. The funders had no role in the design of the study; in the collection, analyses, or interpretation of data; in the writing of the manuscript; or in the decision to publish the results.
References
- Centers for Disease Control. Antibiotic Resistance Threats in the United States. 2019. Available online: www.cdc.gov/DrugResistance/Biggest-Threats.html (accessed on 3 August 2022).
- Ito, A.; Ito, T. Absorption spectra of deoxyribose, ribosephosphate, atp and dna by direct transmission measurements in the vacuum-uv (150—190 nm) and far-uv (190—260 nm) regions using synchrotron radiation as a light source. Photochem. Photobiol. 1986, 44, 355–358. [Google Scholar] [CrossRef]
- Kemmink, J.; Boelens, R.; Koning, T.M.G.; Kaptein, R.; Marel, G.A.; Boom, J.H. Conformational changes in the oligonucleotide duples d(GCGTTGCG). d (CGCAACGC) induced by formation of a cis-syn thymine dimer. A two-dimensional NMR study. Eur. J. Biochem. 1987, 162, 37–43. [Google Scholar] [CrossRef]
- Rycyna, R.E.; Alderfer, J.L. UV irradiation of nucleic acids: Formation, purification and solution conformational analysis of the ‘6-4 lesion’ of dTpdT. Nucleic Acids Res. 1985, 13, 5949–5963. [Google Scholar] [CrossRef]
- Mouret, S.; Philippe, C.; Gracia-Chantegrel, J.; Banyasz, A.; Karpati, S.; Markovitsi, D.; Douki, T. UVA-induced cyclobutane pyrimidine dimers in DNA: A direct photochemical mechanism? Org. Biomol. Chem. 2010, 8, 1706–1711. [Google Scholar] [CrossRef]
- Rideout, W.M.; Coetzee, G.A.; Olumi, A.F.; Jones, P.A. 5-Methylcytosine as an endogenous mutagen in the human LDL receptor and p53 genes. Science 1990, 249, 1288–1290. [Google Scholar] [CrossRef] [PubMed]
- Pfeifer, G.P.; Besaratinia, A. UV wavelength-dependent DNA damage and human non-melanoma and melanoma skin cancer. Photochem. Photobiol. Sci. 2011, 11, 90–97. [Google Scholar] [CrossRef]
- Madson, J.G.; Lynch, D.T.; Tinkum, K.L.; Putta, S.K.; Hansen, L.A. Erbb2 regulates inflammation and proliferation in the skin after ultraviolet irradiation. Am. J. Pathol. 2006, 169, 1402–1414. [Google Scholar] [CrossRef]
- Berhane, T.; Halliday, G.M.; Cooke, B.; Barnetson, R.S.C. Inflammation is associated with progression of actinic keratoses to squamous cell carcinomas in humans. Br. J. Dermatol. 2002, 146, 810–815. [Google Scholar] [CrossRef]
- Fisher, M.S.; Kripke, M.L. Systemic alteration induced in mice by ultraviolet light irradiation and its relationship to ultraviolet carcinogenesis. Proc. Natl. Acad. Sci. USA 1977, 74, 1688–1692. [Google Scholar] [CrossRef]
- Donawho, C.K.; Kripke, M.L. Evidence That the Local Effect of Ultraviolet Radiation on the Growth of Murine Melanomas Is Immunologically Mediated. Cancer Res. 1991, 51, 4176–4181. [Google Scholar]
- Cavanagh, L.L.; Halliday, G.M. Dendritic Epidermal T Cells in Ultraviolet-irradiated Skin Enhance Skin Tumor Growth by Inhibiting CD4+ T-Cell-mediated Immunity. Cancer Res. 1996, 56, 2607–2615. [Google Scholar] [PubMed]
- Bernstein, E.F.; Brown, D.B.; Urbach, F.; Forbes, D.; Monaco, M.D.; Wu, M.; Katchman, S.D.; Uitto, J. Ultraviolet radiation activates the human elastin promoter in transgenic mice: A novel in vivo and in vitro model of cutaneous photoaging. J. Investig. Dermatol. 1995, 105, 269–273. [Google Scholar] [CrossRef]
- Moloney, S.J.; Edmonds, S.H.; Giddens, L.D.; Learn, D.B. The Hairless Mouse Model of Photoaging: Evaluation of the Relationship between Dermal Elastin, Collagen, Skin Thickness and Wrinkles. Photochem. Photobiol. 1992, 56, 505–511. [Google Scholar] [CrossRef]
- Brash, D.E.; Rudolph, J.A.; Simon, J.A.; Lin, A.; McKenna, G.J.; Baden, H.p.; Halperin, A.J.; Pontén, J. A role for sunlight in skin cancer: UV-induced p53 mutations in squamous cell carcinoma. Proc. Natl. Acad. Sci. USA 1991, 88, 10124–10128. [Google Scholar] [CrossRef] [PubMed]
- Conner-Kerr, T.A.; Sullivan, P.; Gaillard, J.-M.; Franklin, M.E.; Jones, R.M. The effects of ultraviolet radiation on antibiotic-resistant bacteria in vitro. Ostomy Wound Manag. 1998, 44, 50–56. [Google Scholar]
- Rao, B.K.; Kumar, P.; Rao, S.; Gurung, B. Bactericidal Effect of Ultraviolet C (UVC), Direct and Filtered Through Transparent Plastic, on Gram-Positive Cocci: An in vitro Study. Ostomy Wound Manag. 2011, 57, 46. [Google Scholar]
- Bak, J.; Ladefoged, S.D.; Tvede, M.; Begovic, T.; Gregersen, A. Dose requirements for UVC disinfection of catheter biofilms. Biofouling 2009, 25, 289–296. [Google Scholar] [CrossRef]
- Enwemeka, C.S.; Williams, D.; Hollosi, S.; Yens, D.; Enwemeka, S.K. Visible 405 nm SLD light photo-destroys methicillin-resistant Staphylococcus aureus (MRSA) in vitro. Lasers Surg. Med. 2008, 40, 734–737. [Google Scholar] [CrossRef]
- Ashkenazi, H.; Malik, Z.; Harth, Y.; Nitzan, Y. Eradication of Propionibacterium acnes by its endogenic porphyrins after illumination with high intensity blue light. FEMS Immunol. Med. Microbiol. 2003, 35, 17–24. [Google Scholar] [CrossRef]
- Murdoch, L.E.; Maclean, M.; Endarko, E.; MacGregor, S.J.; Anderson, J.G. Bactericidal Effects of 405 nm Light Exposure Demonstrated by Inactivation of Escherichia, Salmonella, Shigella, Listeria, and Mycobacterium Species in Liquid Suspensions and on Exposed Surfaces. Sci. World J. 2012, 2012, 137805. [Google Scholar] [CrossRef]
- Ganz, R.A.; Veveiros, B.S.J.; Ahmad, A.; Ahmadi, A.; Khalil, A.; Tolkoff, M.S.J.; Nishioka, N.S.; Hamblin, M.R. Helicobacter pylori in patients can be killed by visible light. Lasers Surg. Med. 2005, 36, 260–265. [Google Scholar] [CrossRef]
- Halstead, F.D.; Thwaite, J.E.; Burt, R.; Laws, T.R.; Raguse, M.; Moeller, R.; Webber, M.A.; Oppenheima, B.A. Antibacterial activity of blue light against nosocomial wound pathogens growing planktonically and as mature biofilms. Appl. Environ. Microbiol. 2016, 82, 4006–4016. [Google Scholar] [CrossRef] [PubMed]
- Amin, R.M.; Bhayana, B.; Hamblin, M.R.; Dai, T. Antimicrobial blue light inactivation of Pseudomonas aeruginosa by photo-excitation of endogenous porphyrins: In vitro and in vivo studies. Lasers Surg. Med. 2016, 48, 562–568. [Google Scholar] [CrossRef] [PubMed]
- Dungel, P.; Mittermayr, R.; Haindl, S.; Osipov, A.; Wagner, C.; Redl, H.; Kozlov, A.V. Illumination with blue light reactivates respiratory activity of mitochondria inhibited by nitric oxide, but not by glycerol trinitrate. Arch. Biochem. Biophys. 2008, 471, 109–115. [Google Scholar] [CrossRef] [PubMed]
- Dungel, P.; Hartinger, J.; Chaudary, S.; Slezak, P.; Hofmann, A.; Hausner, T.; Strassl, M.; Wintner, E.; Redl, H.; Mittermayr, R. Low level light therapy by LED of different wavelength induces angiogenesis and improves ischemic wound healing. Lasers Surg. Med. 2014, 46, 773–780. [Google Scholar] [CrossRef] [PubMed]
- Eichler, M.; Lavi, R.; Shainberg, A.; Lubart, R. Flavins are source of visible-light-induced free radical formation in cells. Lasers Surg. Med. 2005, 37, 314–319. [Google Scholar] [CrossRef] [PubMed]
- Dungel, P.; Hartinger, J.; Chaudary, S.; Slezak, P.; Hofmann, A.; Hausner, T.; Strassl, M.; Wintner, E.; Redl, H.; Mittermayr, R. Phototargeting oral black-pigmented bacteria. Antimicrob. Agents Chemother. 2005, 49, 1391–1396. [Google Scholar]
- McDonald, R.; MacGregor, S.J.; Anderson, J.G.; Maclean, M.; Grant, M.H. Effect of 405-nm high-intensity narrow-spectrum light on fibroblast-populated collagen lattices: An in vitro model of wound healing. J. Biomed. Opt. 2011, 16, 048003. [Google Scholar] [CrossRef] [PubMed]
- Kleinpenning, M.M.; Smits, T.; Frunt, M.H.A.; van Erp, P.E.J.; van de Kerkhof, P.C.M.; Gerritsen, R.M.J.P. Clinical and histological effects of blue light on normal skin. Photodermatol. Photoimmunol. Photomed. 2010, 26, 16–21. [Google Scholar] [CrossRef]
- Costa, R.M.A.; Chiganças, V.; Galhardo, R.D.S.; Carvalho, H.; Menck, C.F.M. The eukaryotic nucleotide excision repair pathway. Biochimie 2003, 85, 1083–1099. [Google Scholar] [CrossRef]
- Miles, A.A.; Misra, S.S. The estimation of the bactericidal power of the blood. Epidemiol. Infect. 1938, 38, 732–749. [Google Scholar] [CrossRef] [PubMed]
- Bunnell, B.E.; Escobar, J.F.; Bair, K.L.; Sutton, M.D.; Crane, J.K. Zinc blocks SOS-induced antibiotic resistance via inhibition of RecA in Escherichia coli. PLoS ONE 2017, 12, e0178303. [Google Scholar] [CrossRef]
- Alam, M.K.; Alhhazmi, A.; Decoteau, J.F.; Luo, Y.; Geyer, C.R. RecA Inhibitors Potentiate Antibiotic Activity and Block Evolution of Antibiotic Resistance. Cell Chem. Biol. 2016, 23, 381–391. [Google Scholar] [CrossRef]
- Bellio, P.; Brisdelli, F.; Perilli, M.; Sabatini, A.; Bottoni, C.; Segatore, B.; Setacci, D.; Amicosante, G.; Celenza, G. Curcumin inhibits the SOS response induced by levofloxacin in Escherichia coli. Phytomedicine 2014, 21, 430–434. [Google Scholar] [CrossRef]
- Baptista, M.S.; Cadet, J.; Di Mascio, P.; Ghogare, A.A.; Greer, A.; Hamblin, M.R.; Lorente, C.; Nunez, S.C.; Ribeiro, M.S.; Thomas, A.H.; et al. Type I and Type II Photosensitized Oxidation Reactions: Guidelines and Mechanistic Pathways. Photochem. Photobiol. 2017, 93, 912–919. [Google Scholar] [CrossRef]
- Guffey, J.S.; Payne, W.; Jones, T.; Martin, K. Evidence of resistance development by Staphylococcus aureus to an in vitro, multiple stage application of 405 nm light from a supraluminous diode array. Photomed. Laser Surg. 2013, 31, 179–182. [Google Scholar] [CrossRef]
- Rapacka-Zdonczyk, A.; Wozniak, A.; Pieranski, M.; Woziwodzka, A.; Bielawski, K.P.; Grinholc, M. Development of Staphylococcus aureus tolerance to antimicrobial photodynamic inactivation and antimicrobial blue light upon sub-lethal treatment. Sci. Rep. 2019, 9, 1–18. [Google Scholar]
- Alcántara-Díaz, D.; Breña-Valle, M.; Serment-Guerrero, J. Divergent adaptation of Escherichia coli to cyclic ultraviolet light exposures. Mutagenesis 2004, 19, 349–354. [Google Scholar] [CrossRef]
- Adamskaya, N.; Dungel, P.; Mittermayr, R.; Hartinger, J.; Feichtinger, G.; Wassermann, K.; Redl, H.; van Griensven, M. Light therapy by blue LED improves wound healing in an excision model in rats. Injury 2011, 42, 917–921. [Google Scholar] [CrossRef]
- Liebmann, J.; Born, M.; Kolb-Bachofen, V. Blue-light irradiation regulates proliferation and differentiation in human skin cells. J. Investig. Dermatol. 2010, 130, 259–269. [Google Scholar] [CrossRef]
- Opländer, C.; Hidding, S.; Werners, F.B.; Born, M.; Pallua, N.; Suschek, C.V. Effects of blue light irradiation on human dermal fibroblasts. J. Photochem. Photobiol. B Biol. 2011, 103, 118–125. [Google Scholar] [CrossRef]
- Krassovka, J.M.; Suschek, C.V.; Prost, M.; Grotheer, V.; Schiefer, J.L.; Demir, E.; Fuchs, P.C.; Windolf, J.; Stürmer, E.K.; Opländer, C. The impact of non-toxic blue light (453 nm) on cellular antioxidative capacity, TGF-β1 signaling, and myofibrogenesis of human skin fibroblasts. J. Photochem. Photobiol. B. 2020, 209, 111952. [Google Scholar] [CrossRef]
- Fyrestam, J.; Bjurshammar, N.; Paulsson, E.; Mansouri, N.; Johannsen, A.; Östman, C. Influence of culture conditions on porphyrin production in Aggregatibacter actinomycetemcomitans and Porphyromonas gingivalis. Photodiagnosis Photodyn. Ther. 2017, 17, 115–123. [Google Scholar] [CrossRef]
- Rieble, S.; Ormerod, J.G.; Beale, S.I. Transformation of glutamate to delta-aminolevulinic acid by soluble extracts of Chlorobium vibrioforme. J. Bacteriol. 1989, 171, 3782–3787. [Google Scholar] [CrossRef]
- Chen, Z.; Yang, H.; Pavletich, N.P. Mechanism of homologous recombination from the RecA-ssDNA/dsDNA structures. Nature 2008, 453, 489–494. [Google Scholar] [CrossRef]
- Friedman, N.; Vardi, S.; Ronen, M.; Alon, U.; Stavans, J. Precise temporal modulation in the response of the SOS DNA repair network in individual bacteria. PLoS Biol. 2005, 3, 1261–1268. [Google Scholar] [CrossRef]
- Little, J.W. Mechanism of specific LexA cleavage: Autodigestion and the role of RecA coprotease. Biochimie 1991, 73, 411–421. [Google Scholar] [CrossRef]
- Horii, T.; Ogawa, T.; Nakatani, T.; Hase, T.; Matsubara, H.; Ogawa, H. Regulation of SOS functions: Purification of E. coli LexA protein and determination of its specific site cleaved by the RecA protein. Cell 1981, 27, 515–522. [Google Scholar] [CrossRef]
- Lewis, L.K.; Harlow, G.R.; Gregg-Jolly, L.A.; Mount, D.W. Identification of high affinity binding sites for LexA which define new DNA damage-inducible genes in Escherichia coli. J. Mol. Biol. 1994, 241, 507–523. [Google Scholar] [CrossRef]
- Cohen, S.E.; Foti, J.J.; Simmons, L.A.; Walker, G.C. The SOS Regulatory Network. EcoSal Plus 2008, 3. [Google Scholar] [CrossRef]
- Sassanfar, M.; Roberts, J.W. Nature of the SOS-inducing signal in Escherichia coli. The involvement of DNA replication. J. Mol. Biol. 1990, 212, 79–96. [Google Scholar] [CrossRef]
- Maiques, E.; Ubeda, C.; Campoy, S.; Salvador, N.; Lasa, I.; Novick, R.P.; Barbe, J.; Penades, J.R. β-lactam antibiotics induce the SOS response and horizontal transfer of virulence factors in Staphylococcus aureus. J. Bacteriol. 2006, 188, 2726–2729. [Google Scholar] [CrossRef] [PubMed]
- Miller, C.; Thomsen, L.E.; Gaggero, C.; Mosseri, R.; Ingmer, H.; Cohen, S.N. SOS response induction by β-lactams and bacterial defense against antibiotic lethality. Science 2004, 305, 1629–1631. [Google Scholar] [CrossRef]
- Aksenov, S.V. Induction of the SOS Response in Ultraviolet-Irradiated Escherichia coli Analyzed by Dynamics of LexA, RecA and SulA Proteins. J. Biol. Phys. 1999, 25, 263–277. [Google Scholar] [CrossRef]
- Rodríguez-Rosado, A.I.; Valencia, E.Y.; Rodríguez-Rojas, A.; Costas, C.; Galhardo, R.S.; Blázquez, J.; Rodríguez-Beltrán, J. Reactive oxygen species are major contributors to SOS-mediated mutagenesis induced by fluoroquinolones. BioRxiv 2018. [Google Scholar]
- Campoy, S.; Hervàs, A.; Busquets, N.; Erill, I.; Teixidó, L.; Barbé, J. Induction of the SOS response by bacteriophage lytic development in Salmonella enterica. Virology 2016, 351, 360–367. [Google Scholar] [CrossRef] [PubMed][Green Version]
- Tang, M.; Shen, X.; Frank, E.G.; O’Donnell, M.; Woodgate, R.; Goodman, M.F. UmuD’2C is an error-prone DNA polymerase, Escherichia coli pol V. Proc. Natl. Acad. Sci. USA 1999, 96, 8919–8924. [Google Scholar] [CrossRef]
- Beaber, J.W.; Hochhut, B.; Waldor, M.K. SOS response promotes horizontal dissemination of antibiotic resistance genes. Nature 2004, 427, 72–74. [Google Scholar] [CrossRef] [PubMed]
- Sterer, N.; Jeffet, U.; Dadoun, A.; Greenstein, R.B.N.; Kohavi, D. Zinc enhances the phototoxic effect of blue light against malodour-producing bacteria in an experimental oral biofilm. J. Med. Microbiol. 2014, 63, 1071–1075. [Google Scholar] [CrossRef] [PubMed][Green Version]
- Oda, Y. Inhibitory effect of curcumin on SOS functions induced by UV irradiation. Mutat. Res. Lett. 1995, 348, 67–73. [Google Scholar] [CrossRef]
- Nautiyal, A.; Patil, K.N.; Muniyappa, K. Suramin is a potent and selective inhibitor of Mycobacterium tuberculosis RecA protein and the SOS response: RecA as a potential target for antibacterial drug discovery. J. Antimicrob. Chemother. 2014, 69, 1834–1843. [Google Scholar] [CrossRef]
- Kogut, M.; Harris, M. Effects of Streptomycin in Bacterial Cultures Growing at Different Rates; Interaction with Bacterial Ribosomes in vivo. Eur. J. Biochem. 1969, 9, 42–49. [Google Scholar] [CrossRef] [PubMed]
- Cozens, R.M.; Tuomanen, E.; Tosch, W.; Zak, O.; Suter, J.; Tomasz, A. Evaluation of the bactericidal activity of β-lactam antibiotics on slowly growing bacteria cultured in the chemostat. Antimicrob. Agents Chemother. 1986, 29, 797–802. [Google Scholar] [CrossRef]
- Eng, R.H.K.; Padberg, F.T.; Smith, S.M.; Tan, E.N.; Cherubin, C.E. Bactericidal effects of antibiotics on slowly growing and nongrowing bacteria. Antimicrob. Agents Chemother. 1991, 35, 1824–1828. [Google Scholar] [CrossRef]
Publisher’s Note: MDPI stays neutral with regard to jurisdictional claims in published maps and institutional affiliations. |
© 2022 by the authors. Licensee MDPI, Basel, Switzerland. This article is an open access article distributed under the terms and conditions of the Creative Commons Attribution (CC BY) license (https://creativecommons.org/licenses/by/4.0/).
